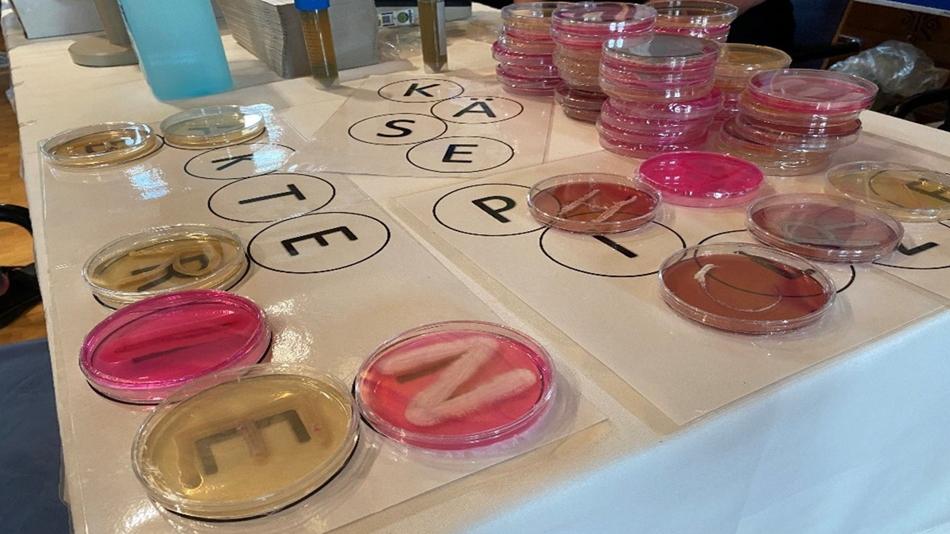
Die Helden der Käseproduktion

Mitmachstation
Wer sind die wahren Helden der Käseproduktion?
Das österreichische Kompetenzzentrum für Futter- und Lebensmittelqualität, -sicherheit und -innovation (FFoQSI) ist ein führendes, anwendungsorientiertes Forschungszentrum. Es entwickelt zukunftsweisende Lösungen entlang der gesamten Wertschöpfungskette - vom Feld auf den Tisch. Im Fokus stehen die Qualität und Sicherheit von Lebensmitteln, nachhaltige Lebensmittelsysteme sowie die digitale Transformation von Lieferketten. Mehrere Forschungsprojekte widmen sich der Sicherheit von Milch und Milchprodukten. Bei der Langen Nacht der Forschung geben wir den Besucherinnen und Besuchern spannende Einblicke in unsere Forschung zur optimierten Herstellung und Reifung österreichischer Käsesorten.
Besucherinformation
Dieser Ausstellungsstandort ist barrierefrei zugänglich und verfügt über barrierefreie Toiletten.
Öffnungszeiten
Kontakt
6 weitere Stationen an diesem Standort
-
MitmachstationAbfall als Ressource - Wie können uns Mikroorganismen und Biomoleküle bei der Metallrückgewinnung unterstützen?NeuThema: Technik UmweltSpezielle Mikroorganismen lösen Metalle aus unterschiedlichen Abfällen, z.B. von alten Handys oder Laptops. Mit Biomolekülen fischen wir die einzelnen Metalle gezielt aus den Mischlösungen heraus – wollt ihr mitangeln?K1-MET GmbH17:00 - 23:00
-
MitmachstationDie Bioaktivitäts-Schatzkammer: Entdecke die geheimen Superkräfte der Naturstoffe!NeuThema: Naturwissenschaften TechnikPflanzen und Mikroben besitzen faszinierende Fähigkeiten – doch ihre Werkzeuge sind für das menschliche Auge unsichtbar. Unsere Hochleistungsgeräte jedoch ermöglichen einen Blick in dieses Archiv der Naturstoffe: Entdecken Sie in unserer interaktiven Molekül-Bibliothek, wie Pflanzen durch Naturstoffe kommunizieren, sich schützen oder Angreifer abwehren und wie wir diese Substanzen analysieren und erforschen.BOKU University17:00 - 23:00
-
MitmachstationDen Tätern auf der Spur… Wie findet man Allergene in Lebensmitteln?NeuThema: Gesundheit NaturwissenschaftenMehr als 17 Millionen Menschen in Europa leiden unter Lebensmittelallergien. Der Verzicht vieler Nahrungsmittel gehört zu ihrem täglichen Leben, entscheidet in besonderen Fällen sogar über ihr Überleben. Aus welchen Gründen beinhalten manche Lebensmittel diese Allergene und wie können sie gefunden werden?BOKU University17:00 - 23:00
-
MitmachstationMit Infrarot auf Spurensuche. Wie hilft Infrarotspektroskopie dabei, Materialien zu unterscheiden, die für uns gleich aussehen?NeuThema: NaturwissenschaftenBei dieser Station wird gezeigt, wie Infrarotspektroskopie Materialien unterscheidbar macht, die für das menschliche Auge identisch wirken. Jedes Material absorbiert unsichtbares Infrarotlicht auf einzigartige Weise und besitzt einen spektralen Fingerabdruck, der eine rasche Identifikation ermöglicht. Bring eine Kunststoffprobe mit und probiere es selbst aus.BOKU University17:00 - 23:00
-
AusstellungWer misst richtig? Wie Forschung durch Ringversuche die Qualität des Wassers in Österreich sichert.NeuThema: Naturwissenschaften UmweltWasseranalysen sind die Grundlage für Umwelt- und Gesundheitsschutz. Doch woher weiß man, dass Messergebnisse stimmen? An unserem Stand zeigen wir, wie Forschende mithilfe von Ringversuchen Laborergebnisse vergleichen, überprüfen und so die Qualität von Wasseranalysen in ganz Österreich sichern.BOKU University17:00 - 23:00
-
MitmachstationWenn der Wasserhahn versiegt - wie sichere ich die Trinkwasserqualität unter Katastrophenbedingungen?NeuThema: Technik UmweltWir erforschen für das Österreichische Bundesheer und das Rote Kreuz Methoden, die Notfall-Wasserversorgung nach Katastrophen oder im Konfliktfall zu überwachen, und sicherzustellen, dass die mobilen Wasseraufbereitungsanlagen sicheres Wasser produzieren. Diese Methoden zeigen mögliche Beeinträchtigungen zeitnah an und tragen damit zum Schutz der Gesundheit der versorgten Bevölkerung bei.Technische Universität Wien17:00 - 23:00